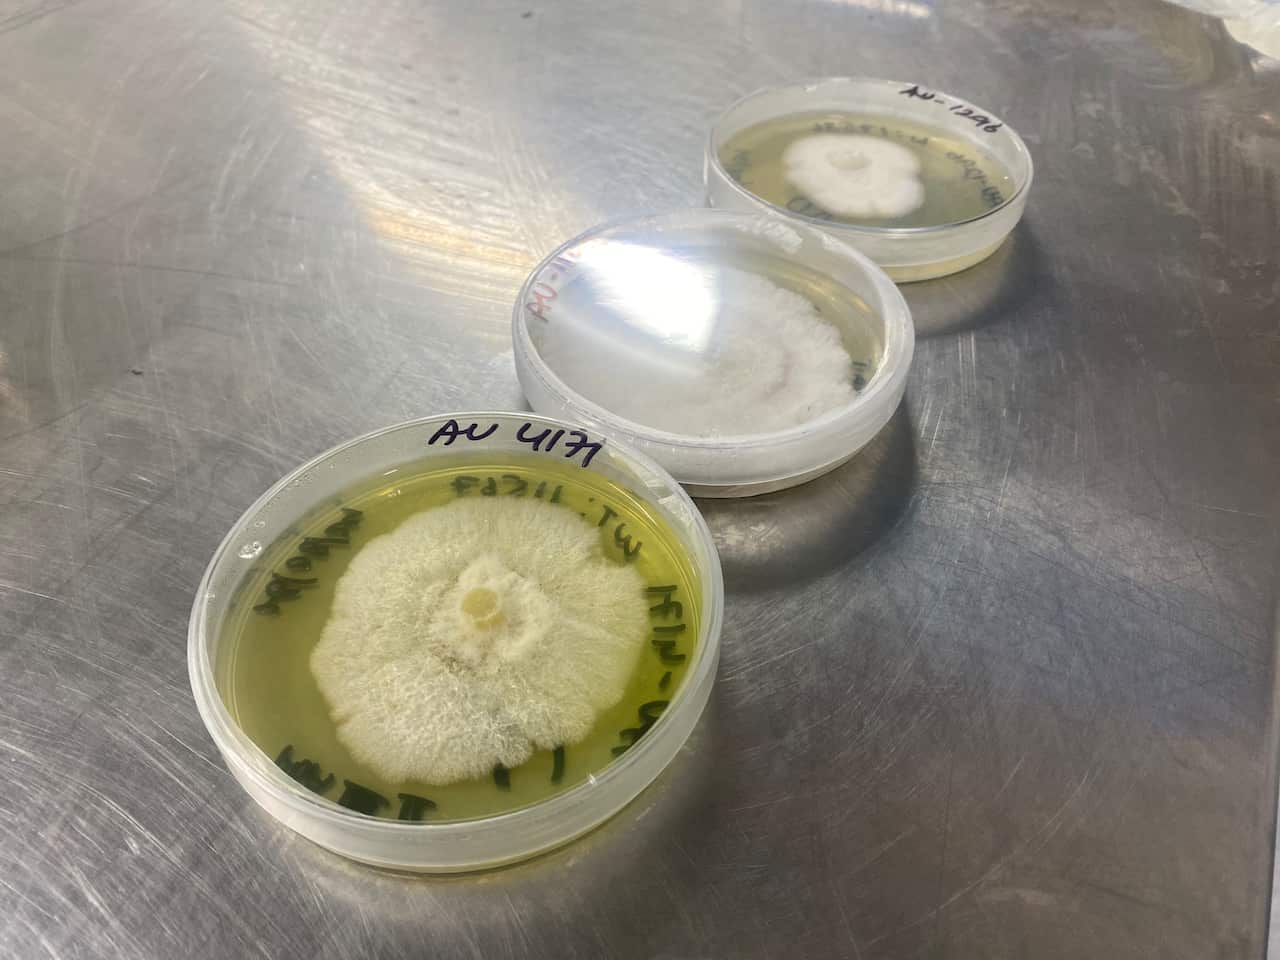
A close-up of fungal spores in three plastic containers.

From above, third-generation farmer Clint Neville's canola fields look like they would during any given growing season: sprawling acres of green and gold.
But below ground, something unusual is taking place.
"Normally when I sow [the seeds] I only get one tap root, but I'm getting all these fine little root systems," he says.
"I think that's the fungi."
Neville's 1,940-hectare farm is located near Forbes in central west NSW. When he first planted the canola crop seven months ago, he coated the seeds in a powder-like ingredient containing live fungi.

"It's just a seed treatment that goes down with the seed at sowing time. It's a pretty simple process," he says.
This minor change to farming operations could have benefits both for the agriculture industry and the planet.
Harnessing the superpowers of fungi
In the nearby town of Orange, a team of scientists, agronomists and carbon project specialists have been studying thousands of species of fungi.
The Loam Bio team, an Australian start-up which began operations in 2019, believes the tiny organisms can play a big role in the fight against climate change — by helping to lock carbon in agricultural soils.
"As we know, there's too much carbon in our atmosphere, but some people don't realise that there's actually not enough carbon within our agricultural soils," Loam Bio co-founder Tegan Nock says.
We focus on technology that lets us pull carbon out of the atmosphere, where it's a problem, and put it into our soils, where it's a solution.
While much remains a mystery about the vast network of fungi beneath our feet, the organisms are known to store large amounts of carbon underground.
The team at Loam Bio is seeking to harness this superpower.
Last year, after almost five years of research in the lab, greenhouse and field, the company released a fungi-based product for crop farmers to help their soils retain the carbon absorbed by plants.
Plants draw carbon dioxide from the air through a process known as photosynthesis, but most of it is eventually released back into the atmosphere.
The seed treatment — made from fungal spores that attach to the plant — is designed to keep the carbon underground.
"As the plant grows, it establishes a symbiosis with the fungi — and carbon gets pulled down through the plant into the soil and stabilised in the soil by the fungi," Loam Bio's biologist and chief product officer Robbie Oppenheimer says.
The potential benefits are twofold: less carbon in the atmosphere and healthier, more resilient crops.
Nock says: "We're really excited about the impact that a product like this can have — both from a climate perspective, but also just from a food systems perspective."
"We're really eager to be able to see it scaled right across agricultural landscapes."
Loam Bio is working heavily in Australia, with research and trial programs underway in the United States and Brazil.

Fungi: the 'fifth kingdom of life'
The term fungi is thought to cover millions of species — including mushrooms — and has been classified as a fifth and separate kingdom of organisms.
These species are everywhere — living underneath grasslands, forests, roads, gardens and houses across every continent.
"Fungi are their own kingdom of life. You have animals, you have plants — you also have fungi," says Katie Field, a professor of plant-soil processes at the University of Sheffield in England.
"[But] we know relatively little about fungi in comparison to other kingdoms of life."
Field was involved in research, published last year, which looked at how much carbon the earth's subterranean fungi is storing.
The international team of scientists found an estimated 13 gigatonnes of carbon is transferred from plants to the global fungi network annually. That's roughly equivalent to a third of global fossil fuel emissions.
"It's massive … the number is hard to comprehend. And this is just happening below our feet every day, unknown, silently," Field says.
She believes there is potential to increase carbon stocks in soils through fungi.
"There's definitely great potential for fungi to contribute to the efforts to mitigate climate change by moving carbon from the atmosphere below ground and potentially storing it," Field says.
But she says the role that fungi play in keeping carbon in the soil is "still very much under investigation".
"When we talk about fungi holding onto carbon and using those big numbers, we have to remember that that is at a given point in time," she says.
"We don't know the fate of that carbon and how long it lasts within the soil. We know some of it sticks around, but we don't really know how much or for how long."
Field advocates for better agricultural management strategies, such as cover cropping (crops planted to improve soil rather than for harvesting) or minimal use of fertilisers, to protect existing fungi networks rather than adding inoculants (bacteria) to soils.
She says the seed treatment could still play a role: in "mitigating some of the CO2 that will come into the atmosphere".
"I think it's a very exciting and promising target. Agricultural soils have this huge potential. Maybe [the product], in addition to changing [agricultural] management practices, has some synergistic benefits."
But Field acknowledges the scale of the climate crisis is "so vast".
"It's going to take a global effort and there's not going to be any one solution."

Is the fungi treatment working?
So far, the fungi treatment has been scattered across 40,000 hectares of farmland in Australia. That figure is expected to increase to 250,000 by the end of 2025.
Agricultural scientist Warwick Badgery says while fungi is a "valid mechanism for building carbon", it's too soon to say if the technology works — and more evidence is needed.
"It's complex to predict outcomes. You need long periods of data to have confidence that sequestration (capturing and storing carbon) will occur and be able to be maintained in a system long term," he says.
The government's independent body, the Climate Change Authority, defines sequestration as the capture and storage of carbon.
Badgery says measuring carbon stocks in soils is challenging due to variability, including from weather events like droughts and floods.
Nock, from Loam Bio, acknowledges the technology is not a "silver bullet" to address the climate crisis.
"It's not the answer to climate change, but it is something that helps buy us time."

Meanwhile, Neville has signed a 25 year contract with the company and has completed a one-year trial of the product on his canola, wheat and barley crops.
"So far, so good," he says of the results.
Neville hopes the seed treatment will not only improve his soil health, but also allow him to earn carbon credits.
"If you can get a yield benefit, build some carbon and get a healthier plant, then that's going to help profitability," he says.
In February, just after harvest, a team from Loam Bio will measure the carbon in Neville's soil, and compare it to baseline levels before the seed treatment was added.
While it's early days, Neville is optimistic.
"The concept of being able to draw carbon out of the atmosphere, take it down through the plant and lock in the soil and hopefully build genuine soil carbon is an exciting process."

